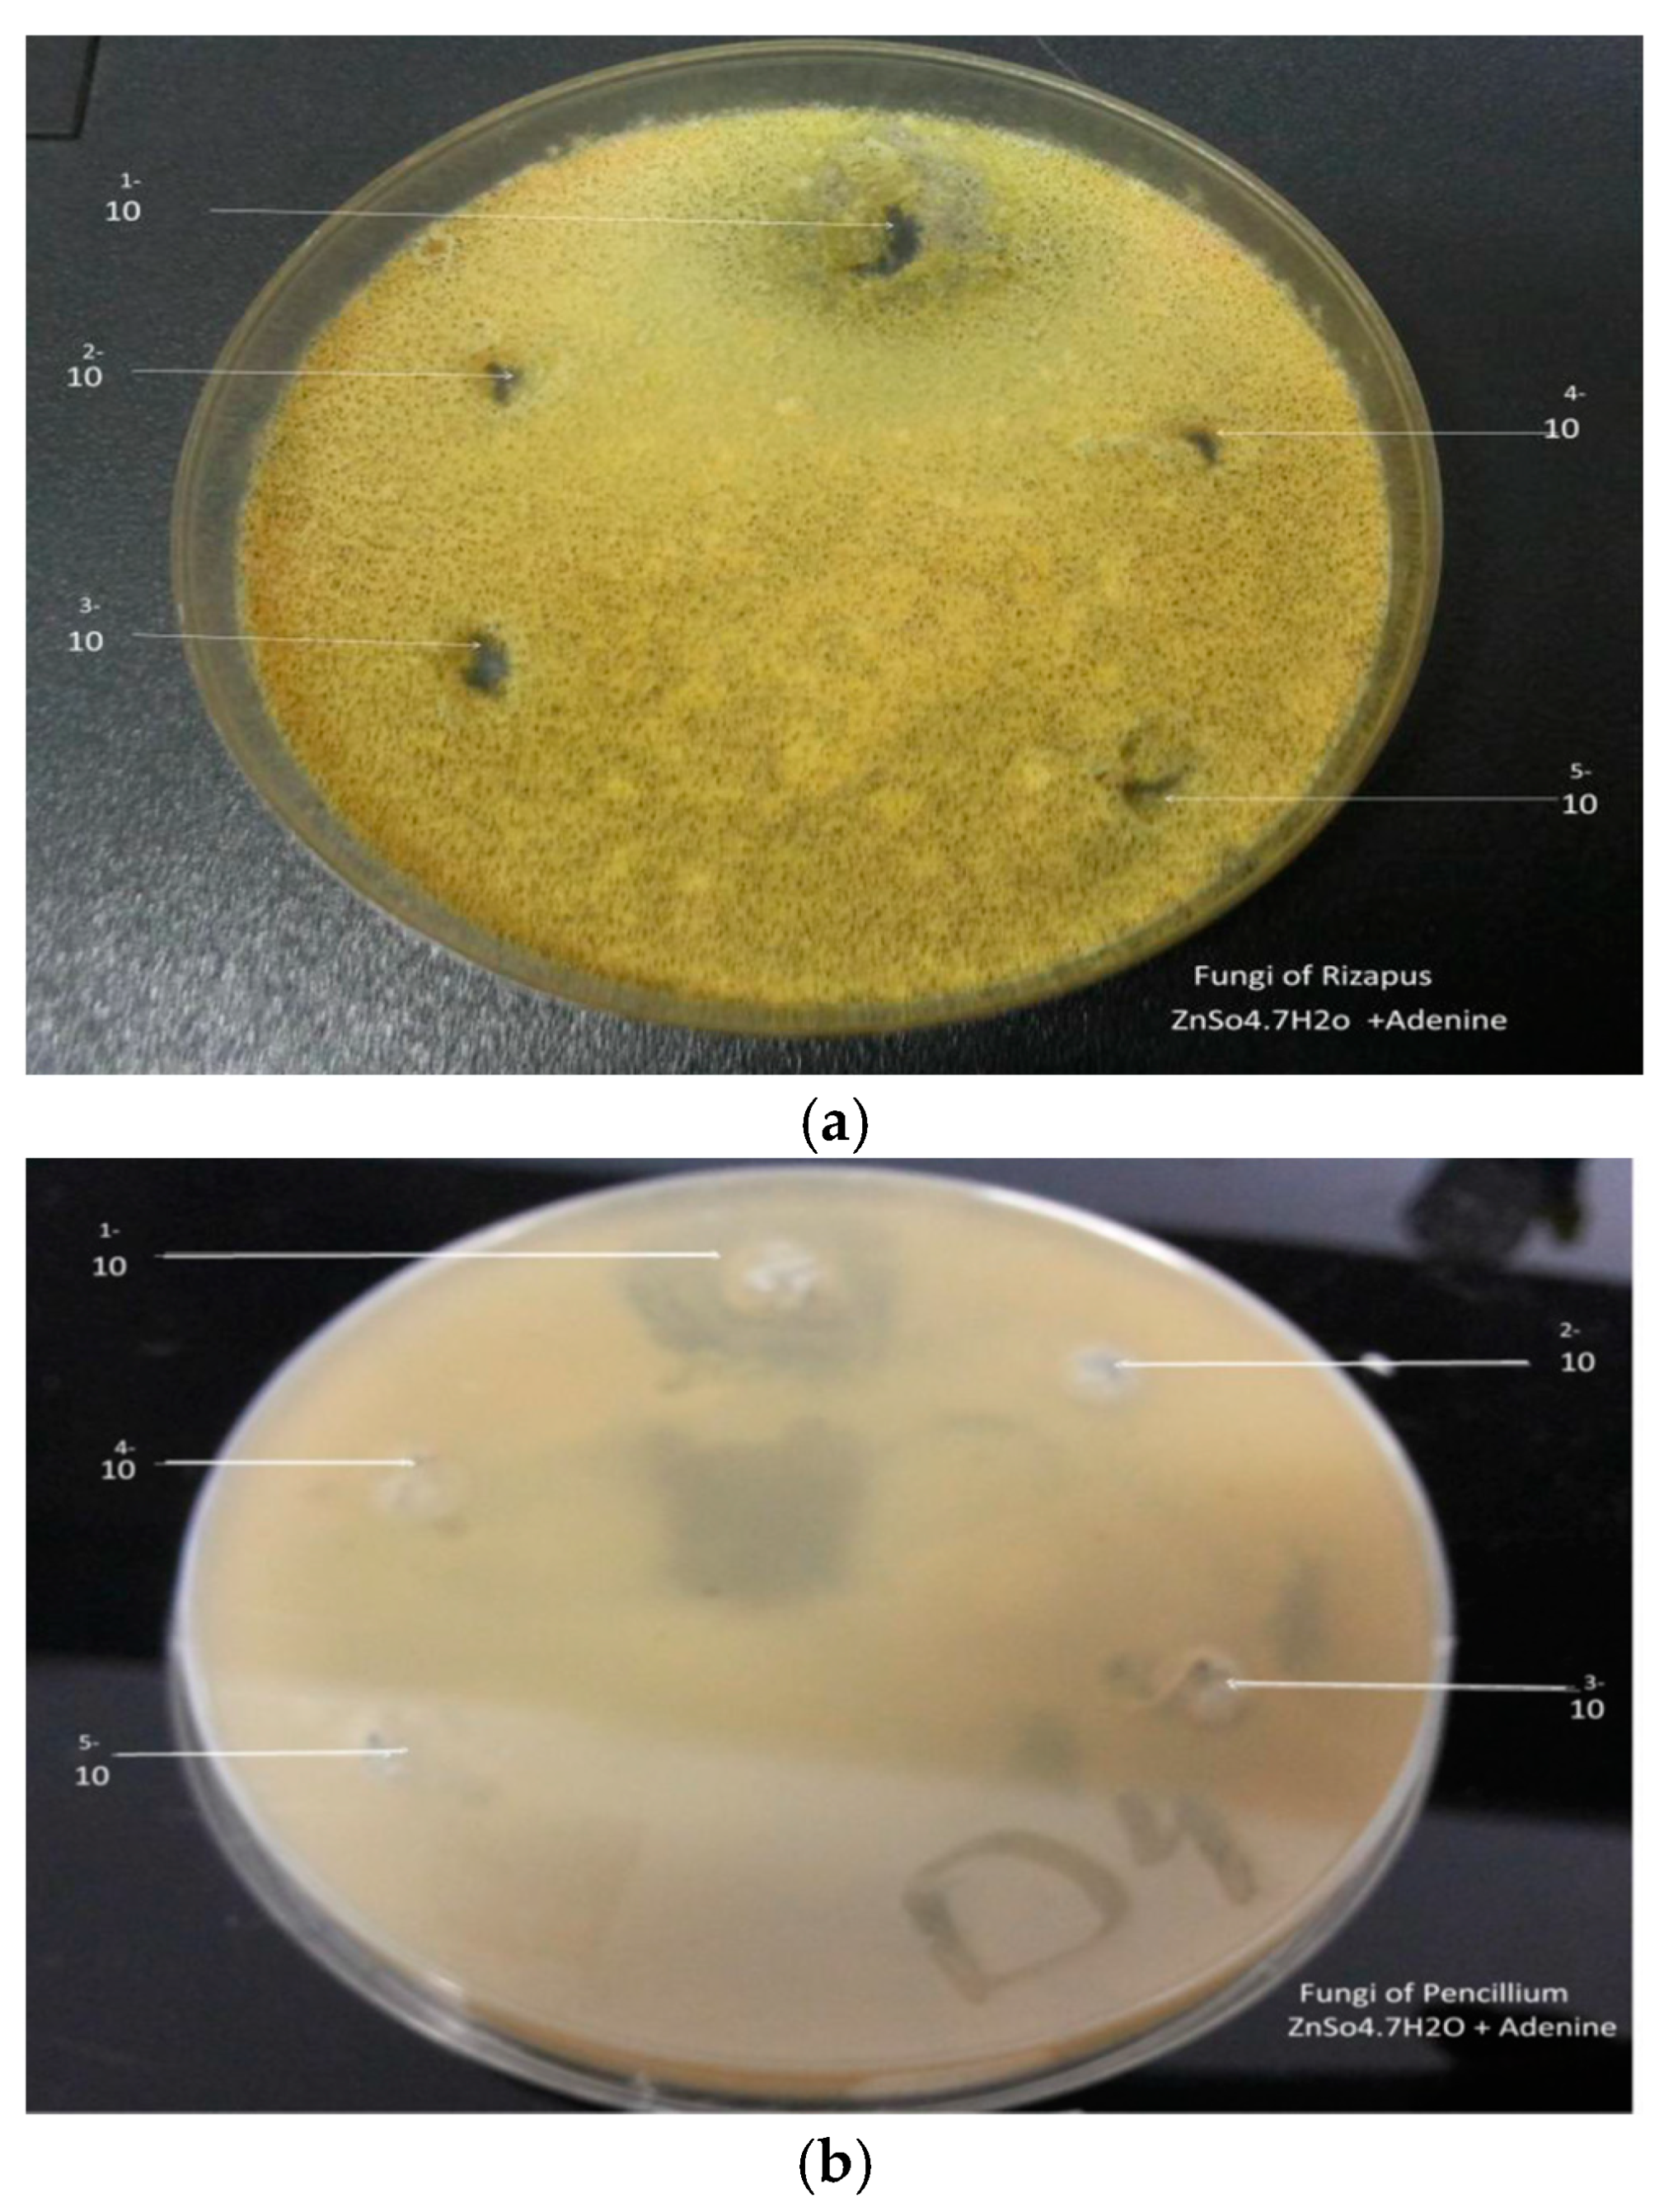

Biological Study of Transition Metal Complexes with Adenine Ligand †
Abstract
:1. Introduction
1.1. Adenine Metal Complexes and Its Binding Sites
1.2. Adenine Metabolism
2. Experimental
2.1. Synthesis of the Metal Complexes
2.2. Antimicrobial Studies
2.3. Bacterial & FUNGI Cultures
3. Result and Discussion
3.1. General Properties
3.2. Infrared Spectral Analysis
3.3. Thermal Decomposition
3.4. Effect of Solvents on the Electronic Spectra of the Adenine
3.5. Molar Absorbance
3.6. Antimicrobial Activity
4. Conclusions
Funding
References
- Dilip, C.S.; Thangaraj, V.; Raj, A.P. Synthesis, spectroscopic characterization, biological and DNA cleavage properties of complexes of nicotinamide. Arab. J. Chem. 2016, 9, 5731–5742. [Google Scholar]
- Zaworotko, M.J.; Hammud, H.H.; Kabbani, A.; McManus, G.J.; Ghannoum, A.M.; Masoud, M.S. Mamdouh, Synthesis and Characterization of Some Transition Metal Complexes with Mixed Adenine and Acetylacetonate Ligands: Crystal Structures of Solvated Complex {[Cu(acac)2(adenine)]_EtOH} and {[Cu(acac)2(adenine)]_DMF_H2O}. J. Chem. Crystallogr. 2009, 39, 853–863. [Google Scholar] [CrossRef]
- El Azzouzi1, N.; El Fadli, Z.; Metni, R.M. Synthesis and chemical characterization of some transition metal complexes with a 6-acetyl-1,3,7-trimetyllumazine ligand. J. Mater. Environ. Sci. 2017, 12, 4323–4328. [Google Scholar] [CrossRef]
- Köse, D.A.; Necefoglu, H. SYNTHESIS AND CHARACTERIZATION OF BIS(NICOTINAMIDE) m-HYDROXYBENZOATE COMPLEXES OF Co(II), Ni(II), Cu(II) AND Zn(II). J. Therm. Anal. Calorim. 2008, 93, 509–514. [Google Scholar] [CrossRef]
- Lawal1, A.; Ayanwale, A.P.; Obaleye, A.J.; Rajee, O.A.; Babamale, F.H.; Lawal, M. Synthesis, Characterization and Biological Studies of Mixed Ligands Nicotinamide-Trimethoprim Complexes. Int. J. Chem. Mater. Environ. Res. 2017, 4, 97–101. [Google Scholar]
- García-Terán, J.P.; Castillo, O.; Luque, A.; García-Couceiro, U.; Román, P.; Lloret, F. One-Dimensional Oxalato-Bridged Cu(II), Co(II), and Zn(II) Complexes with Purine and Adenine as Terminal Ligands. Inorg. Chem. 2004, 43, 5761–5770. [Google Scholar] [CrossRef] [PubMed]
- Marlin, D.S.; Olmstead, M.M.; Mascharak, P.K. Structure−Spectroscopy Correlation in Distorted Five-Coordinate Cu(II) Complexes: A Case Study with a Set of Closely Related Copper Complexes of Pyridine-2,6-dicarboxamide Ligands. Am. Chem. Soc. 2001, 40, 7003–7008. [Google Scholar] [CrossRef] [PubMed]
- Poltronieri, P.; Čerekovic, N. Roles of Nicotinamide Adenine Dinucleotide (NAD+) in Biological Systems. Challenges 2018, 9, 3. [Google Scholar] [CrossRef]
- Ghose, R. Interaction of carbonylchlorohydridotris (triphenylphosphine) ruthenium (II) with purine, adenine, cytosine and cytidine. J. Chem. Res. 2004, 2004, 257–260. [Google Scholar] [CrossRef]
- Kremplova, M.; Fialova, D.; Nejdl, L.; Hynek, D.; Trnkova, L.; Hubalek, J.; Kizek, R.; Adam, V. Influence of Magnetic Microparticles Isolation on Adenine Homonucleotides Structure. Materials 2014, 7, 1455–1472. [Google Scholar] [CrossRef] [PubMed]
- Di Stefano, M.; Conforti, L. Diversification of NAD biological role: The importance of location. FEBS J. 2013, 280, 4711–4728. [Google Scholar] [CrossRef] [PubMed]
- Onori, G.; Blidaru, D. Optical Spectroscopic Study of the Cu(II) Complexes with Adenosine and Adenine Nueleotides. IL Nuova Cimento D 1985, 5, 339–347. [Google Scholar] [CrossRef]
- Lomozik, L.; Gasowska, A.; Basinski, K.; Bregier-Jarzebowska, R.; Jastrzab, R. Potentiometric and spectral studies of complex formation in the Cu(II), 3′,5′-cyclic adenosine monophosphate, and tetramine systems. J. Coord. Chem. 2013, 66, 261–273. [Google Scholar] [CrossRef]
- Shaker, S.A.; Farina, Y.; Mahmmod, S. Synthesis and Characterization of Mixed Ligand Complexes of Caffeine, Adenine and Thiocyanate with Some Transition Metal Ions. Sains Malays. 2010, 39, 957–962. [Google Scholar]
- Clinical & Laboratory Standards Institute (CLSI). M07-A8 Method for Dilution Antimicrobial Susceptibility Tests for Bacteria that Grow Aerobically, 8th ed.; Clinical & Laboratory Standards Institute (CLSI): Wayne, PA, USA, 2009; ISBN 1-56238-689-1. [Google Scholar]
- Ilavarasi, R.; Muthulakshmi, L. Synthesis and Characterization of Platinum(II) Mixed Ligand Complexes of Purines And N-Glycylglycine. Int. J. ChemTech Res. 2014, 6, 1499–1514. [Google Scholar]
- Cui, Y.; Gong, Y.J.; Su, L.; Wu, C.K.; Pang, S.B.; Feng, S.L. Spectroscopy studies of sandwich-type complex of silver(I) coordinated to nuclear fast red and adenine and its analytical applications. Chem. Pap. 2015, 69, 510–517. [Google Scholar] [CrossRef]
- Masoud, M.; El-Merghany, A.; Ramadan, A.; Abd El-Kaway, M. Thermal studies of some purine compounds and their metal complexes. J. Therm. Anal. Calorim. 2010, 101, 839–847. [Google Scholar] [CrossRef]
- Irani, S.; Atyabi, S.M.; Mivehchi, H.; Siadat, S.D.; Aghasadeghi, M.R.; Farhangi, A. Solvent effects on structural and thermochemical properties of p53 tumor-suppressor gene: A molecular modeling approach in drug design. Int. J. Nanomed. 2011, 6, 2063–2069. [Google Scholar]
- De La Rubia, T.; Gonzalez-Lopez, J.; Moreno, J.; Martinez-Toledo, M.V.; Ramos-Cormenzana, A. Adenine nucleotide content and energy charge of Bacillus megaterium during batch growth in low-phosphate medium. FEMS Microbiol. Lett. 1986, 35, 5–9. [Google Scholar]

| Complex | Color | E.C (µs) | M.P °C | Metal Content ppm |
|---|---|---|---|---|
| Adenine | White | 0.17 | 364 | - |
| Adenine-Mn(II) | Black | 1.33 | 135 | 0.50 |
| Adenine-Fe(III) | Brown | 1.10 | >375 | 0.32 |
| Adenine-Co(II) | Brown | 051 | >375 | 0.18 |
| Adenine-Ni(II) | Brown | 1.15 | >375 | 0.09 |
| Adenine-Cu(II) | Blue | 0.17 | >375 | 0.62 |
| Adenine-Zn(II) | White | 1.35 | 295 | 0.40 |
| Adenine-Cd(II) | White | 1.24 | 177 | 0.19 |
| Complex Group | Mn(II)Ad | Fe(III) Ad | Co(II) Ad | Ni(II) Ad | Cu(II) Ad | Zn(II) AD | Cd(II) Ad | Free Adenine |
|---|---|---|---|---|---|---|---|---|
| NH2 | 3287 | 3291 | - | - | - | - | 3322 | 3259 |
| NH aromatic | 3120 | 3114 | 3183 | 3172 | 3147 | 3114 | 3178 | 3554 |
| C=N | 1698 | - | - | 1640 | 1657 | 1642 | 1638 | 1596–1666 |
| CH2 | 1399 | 1450 | - | 1451 | 1402 | 1399 | 1333 | - |
| C-N | 1227 | 1156 | 1203 | 1250 | 1252 | 1223 | 1198 | 1250 |
| =CH | 955 | 1023 | 973 | 975 | 938 | 1059 | 1039 | - |
| C-C | 1460 | 1417 | 1300 | 1400 | 1402 | 1474 | 1415 | 1416 |
| C=C | 1606–1636 | 1667 | 1600 | 1601 | 1657 | 1442 | 1638 | 1596 |
| Complex | Temp. Range °C | Temp. Range °C | Temp. Range °C | Temp. Range °C | Temp. Range °C | Temp. Range °C |
|---|---|---|---|---|---|---|
| Adenine-Mn(II) | 116–66.1 | 314–155 | 314.7–416.7 | - | 416–999.82 | - |
| Adenine-Fe(III) | 22.16–230 | 230.9–335.87 | 336.8–477.1 | 478–605 | 606.5–784 | - |
| Adenine-Co(II) | 38.32–117.3 | 117.8–277.3 | 277.8–400.17 | - | 410–975.8 | - |
| Adenine-Ni(II) | 22.3–107.9 | 108.4–298 | 298.4–461 | - | - | - |
| Adenine-Cu(II) | 22.5–225.3 | 262–622.97 | - | - | 624–999.1 | - |
| Adenine-Zn(II) | 48.6–266.2 | 267.1–999 | - | - | - | - |
| Adenine-Cd(II) | 23.25–137.7 | 138.7–363.7 | 364.7–493.6 | 494–651 | 652.5–829 | 830–920 |
| Solvent | λ Maximum (in nm) of Adenine. |
|---|---|
| Water | 202 |
| DMF | 205 |
| Methanol | 204, 208, 218 |
| Ethanol | 205 |
| DMSO | 256 |
| Sample | Rizapus | Pencillium | ||||||||||||
|---|---|---|---|---|---|---|---|---|---|---|---|---|---|---|
| Complexes | Complexesa | |||||||||||||
| Concentration | 1 | 2 | 3 | 4 | 5 | 6 | 7 | 1 | 2 | 3 | 4 | 5 | 6 | 7 |
| 1 g/10 mL | - | 30 | 35 | - | 15 | 17 | - | - | 49 | 15 | 27 | 26 | 32 | - |
| 1 mL/9 mL | - | 25 | 14 | - | 13 | - | - | - | 20 | 12 | 26 | 15 | 21 | - |
| 1 mL/9 mL | - | - | - | - | 13 | - | - | - | - | - | 30 | 14 | 19 | - |
| 1 mL/9 mL | - | - | - | - | 12 | - | - | - | - | - | 22 | - | 17 | - |
| 1 mL/9 mL | - | - | - | - | - | - | - | - | - | - | 18 | - | 15 | - |
| Sample | Bacillus | E. coli | ||||||||||||
|---|---|---|---|---|---|---|---|---|---|---|---|---|---|---|
| Complexes | Complexesa | |||||||||||||
| Concentration | 1 | 2 | 3 | 4 | 5 | 6 | 7 | 1 | 2 | 3 | 4 | 5 | 6 | 7 |
| 1 g/10 mL | - | 30 | 24 | 24 | 16 | 29 | - | 22 | 25 | 23 | 23 | - | - | 20 |
| 1 mL/9 mL | - | 23 | 22 | - | - | - | - | 19 | 24 | 16 | - | - | - | - |
| 1 mL/9 mL | - | 20 | 17 | - | - | - | - | 17 | 21 | 13 | - | - | - | - |
| 1 mL/9 mL | - | 18 | 15 | - | - | - | - | 16 | 19 | - | - | - | - | - |
| 1 mL/9 mL | - | 15 | 14 | - | - | - | - | 12 | 14 | - | - | - | - | - |
Disclaimer/Publisher’s Note: The statements, opinions and data contained in all publications are solely those of the individual author(s) and contributor(s) and not of MDPI and/or the editor(s). MDPI and/or the editor(s) disclaim responsibility for any injury to people or property resulting from any ideas, methods, instructions or products referred to in the content. |
© 2019 by the authors. Licensee MDPI, Basel, Switzerland. This article is an open access article distributed under the terms and conditions of the Creative Commons Attribution (CC BY) license (https://creativecommons.org/licenses/by/4.0/).
Share and Cite
Hasan, H.M.I.; Yahiya, A.I.; Hassan, S.S.; Salama, M.M. Biological Study of Transition Metal Complexes with Adenine Ligand. Proceedings 2019, 41, 77. https://doi.org/10.3390/ecsoc-23-06601
Hasan HMI, Yahiya AI, Hassan SS, Salama MM. Biological Study of Transition Metal Complexes with Adenine Ligand. Proceedings. 2019; 41(1):77. https://doi.org/10.3390/ecsoc-23-06601
Chicago/Turabian StyleHasan, Hamad M. I., Aaza I. Yahiya, Safaa S. Hassan, and Mabrouk M. Salama. 2019. "Biological Study of Transition Metal Complexes with Adenine Ligand" Proceedings 41, no. 1: 77. https://doi.org/10.3390/ecsoc-23-06601
APA StyleHasan, H. M. I., Yahiya, A. I., Hassan, S. S., & Salama, M. M. (2019). Biological Study of Transition Metal Complexes with Adenine Ligand. Proceedings, 41(1), 77. https://doi.org/10.3390/ecsoc-23-06601
